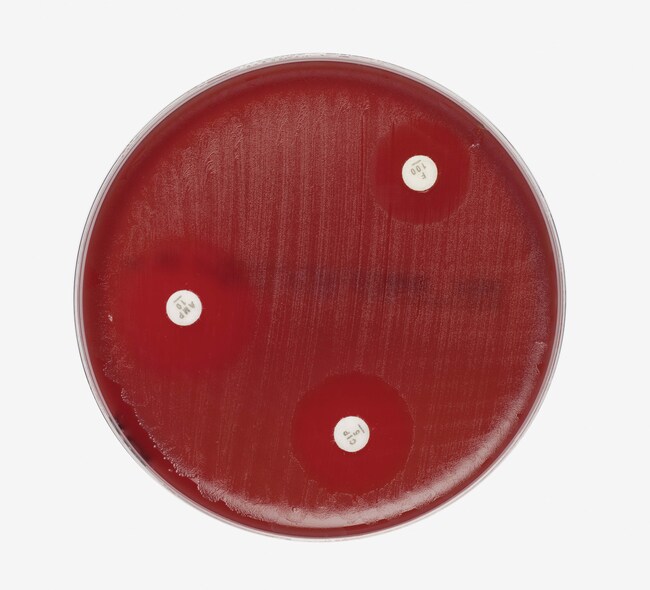
Mueller-Hinton Agar with 5% Sheep Blood

Search
Mueller-Hinton Agar with 5% Sheep Blood
Perform effortless Antimicrobial Susceptibility Tests (AST) for fastidious organisms using prepared plates which conform to CLSI standard.
| Catalog Number | Fill Weight |
|---|---|
| PB0431A | 26.0g ±1.0.g |
Catalog number PB0431A
Price (CNY)
-
Fill Weight:
26.0g ±1.0.g
Perform effortless Antimicrobial Susceptibility Tests (AST) for fastidious organisms using Thermo Scientific™ Mueller-Hinton Agar with 5% Sheep Blood prepared media plates. A precise clear zone will help to determine if the bacteria is resistant or sensitive to the antibiotics used. Mueller-Hinton Agar with 5% Sheep Blood conforms to the American standard of the Clinical and Laboratory Standards Institute (CLSI) and European Standard of Deutsches Institut für Normung (DIN).
The major use of Mueller-Hinton Agar with 5% Sheep Blood is for Antimicrobial Susceptibility Testing (AST). The medium is designed and manufactured according to CLSI standards and can be used in internationally recognised standard procedures.
The inclusion of starch in the medium ensures that toxic factors produced during microbial growth will be absorbed, and its presence is often essential to establish growth from very small inocula.
Not all products are available for sale in all territories. Please inquire.
The inclusion of starch in the medium ensures that toxic factors produced during microbial growth will be absorbed, and its presence is often essential to establish growth from very small inocula.
Not all products are available for sale in all territories. Please inquire.
For In Vitro Diagnostic Use.
For In Vitro Diagnostic Use.
Specifications
ColorTraffic red, opaque
DescriptionMueller-Hinton Agar with 5% Sheep Blood
Fill Weight26.0g ±1.0.g
Format90 mm Monoplate
Packaging TypeWrapped in single cellulose-based film wrap
Quantity10/Pk.
Shelf Life8 Weeks
Product TypeAgar Plate
Unit SizeEach
Contents & Storage
2°C to 10°C